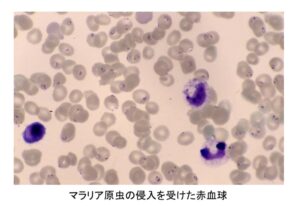

松岡先生の講演と感染症カルタ大会
- 2026年3月28日
- クリニック業務
「暑さ、寒さも彼岸まで」という諺どおり、だいぶ過ごしやすくなってきましたね。
さて、そんな折、お彼岸の翌日、3月21日の日、「感染症かるた大会」なるものを開催しました。
カルタ大会の前に、松岡先生から、「私が熱帯病をこころざした理由」という題でお話をいただきました。
松岡先生は、高校3年生の半ば過ぎまでは「東大の理科2類に進んで、水産の研究でもしようかな」と思っていたとのことでした。ところが、当時松岡青年が憧れていた女性が、ネパールで結核で苦しむ人のために働いていた岩村昇先生の著書を読んで感動し、「松岡君にもお医者さんになってもらって、ネパールの人の力になって欲しいなあ」と言ったとのことです。その女性の自宅近くの風越山を見ながら、医師になって結核で苦しむ人のために働く決意をしたとのことでした。なお、医学部進学、医師になってからも、松岡先生はその女性に時々アプローチしていて、ついに松岡夫人となったとのことです。浮いた話も多い医師の世界にあって、松岡医師は今でも奥さん一筋なのです。もちろん、お子さんがいらっしゃる講演の中では奥さんがらみの話は出ず、この話は松岡先生の許可を得て、掲載させていただいております。
いい仕事をする方は夫婦愛が強いと感じていますが、まさに松岡先生は典型ですね。

松岡先生はネパールへの思いがきっかけとなり、インドネシアにJICA経由で行き、マラリアについての治療、研究をすることになります。
松岡先生の講演はこれで4回目でしょうか?そのたびに新たに啓蒙されることがあるのです。今回は、1.なぜ熱帯地域にマラリアが流行しやすいのかということと、2.なぜ重症化すると死亡することがあるのか ということについて新たに考えさせられました。
1については、冬がくると人の血を吸って流行の原因となっていた蚊がいなくなり、その間にマラリアにかかっていた人がいたとしても媒介することがないので、大流行しないで済んでいるということでした。多くの人にとって、冬は寒いし、雪が降る地方にいたら積雪対策も大変ですが、冬の恵みも受けているのですね。
2については、マラリア原虫は赤血球に住み着き、形を変性させて血管に張り付きやすくなって、血の巡りを悪くさせてしまいます。それで脳の血管を詰まらせて脳症を起こさせたり、臓器を虚血に陥らさせてその臓器がネクローシスといって腐らせてしまうことがあるからです。
奥の深い松岡先生のお話ですが、集まったお子さんが保育園、小学校低学年のお子さんもいらしたため、集中力が続かず、端折ってしまったとのことでした。
今度は、中高生や医療系の学生さんを招いてしたいですね。
お子さんたちもカルタ大会になったら、札そのものを取るのが面白いらしく、元気よく参加してくれました。
カルタ大会に使った「感染症カルタ」は、なんと「江戸東京たてもの園」という一見感染症とは無関係なところで売っていたのです。開業前に遊びに行って見つけ、「開業したらこれで『カルタ大会』をしよう!」と購入したわけでした。内容はかなり高度で、私自身、初めて知ったことも多かったです。
今回で2回目の開催となりました。3回目も、近年中にやりたいなあ。



